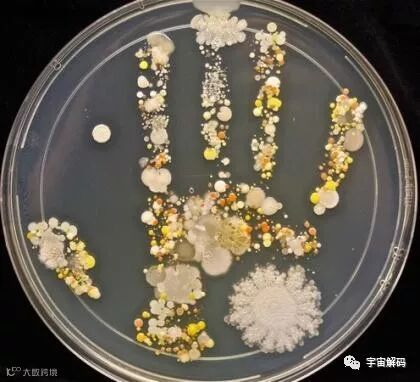
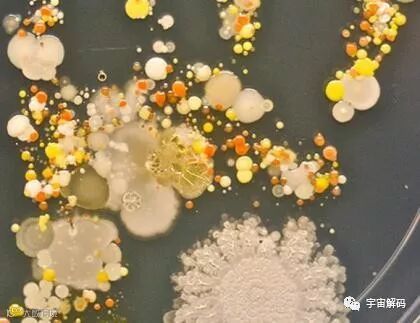

大人总是叮咛「出去玩回家一定要洗手」!可小孩子根本没放在心上啊~手是能多脏啦齁,吃进一点细菌也没差,整整肠刚好而已啊~
不过美国加州Cabrillo大学(Cabrillo College)的实验室技师Tasha Sturm 、做了简单实验。
她让自己8岁儿子在外面玩回来后,在放满寒天的培养品上盖手印,结果最奇妙的手印慢慢形成了..
压手印后数日,培养皿上的微生物开始快速成长,成为一个个群集


真的蛮恶心的...但你能想像吗?要是你回来不洗手直接吃东西,这些细菌就会这样吃进你的肚子...

虽然手上有细菌很正常,真的怕到了...决定以后回家会乖乖洗手囧!

您若有融资需求 请点击阅读原文了解更多……






